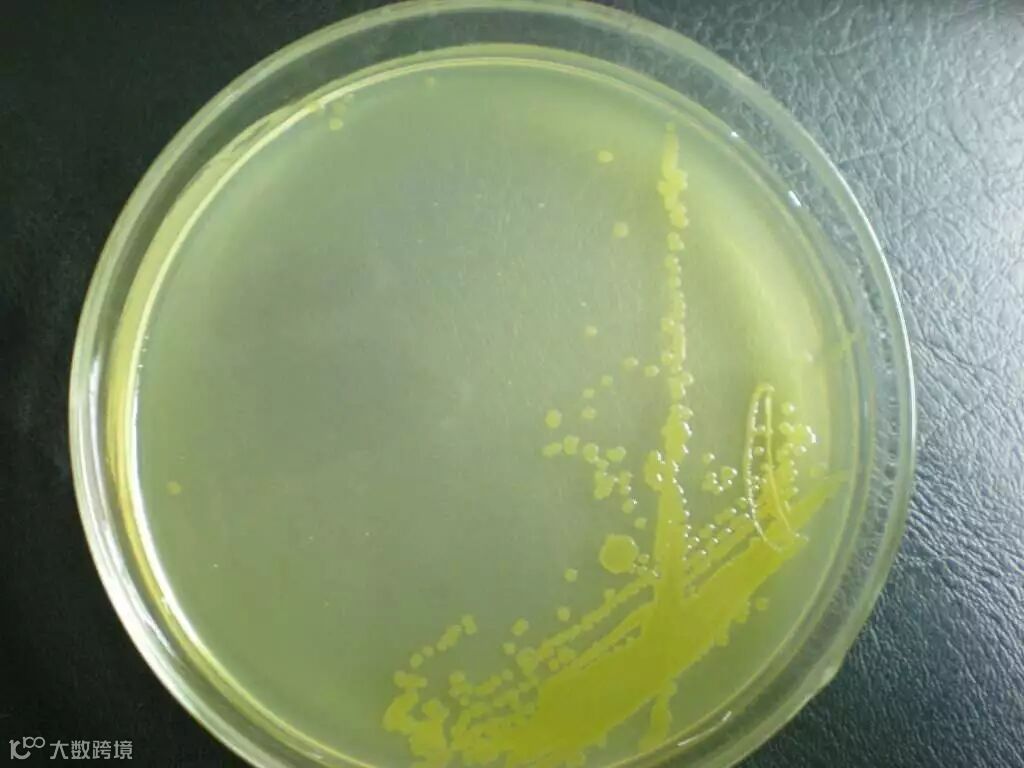

BBR生化工艺在城市生活污水的应用中主要有以下三个特点:
●BBR工艺的核心是使用Bacillus菌(芽孢杆菌属)作为系统的优势菌属
●为了满足Bacillus菌的生长环境条件,BBR工艺采用生物膜法(BBR装置)和活性污泥法(BBR生化池)相结合的组合生化处理工艺。
●BBR生化工艺出水可以满足《城镇污水处理厂污染物排放标准》(GB18918-2002)一级A标准。

一:BBR工艺流程
BBR工艺流程如下图所示:

首先经过预处理的污水进入BBR装置(生物膜法装置),在BBR装置中,通过附着在BBR装置载体表面上的Bacillus菌吸附和分解进水中的有机物、氨氮和磷酸盐。BBR装置对有机物的去除率一般可以达到40-75%。
BBR装置自流入BBR生化池,在BBR生化池内,通过对溶解氧等条件的控制,保证Bacillus菌处于优势地位,最大可能发挥其高效去除有机物、磷和氮的能力。
BBR生化池的出水自流入二沉池,在二沉池内泥水进行分离。上清液达标排放。
根据Bacillus菌生长的需要和工艺特点,需要沉淀池污泥回流(污泥回流)和BBR生化池出水进行回流(内回流),污泥回流和内回流均至BBR设备前。
为了保持Bacillus菌的高活性,需要在BBR设备之前投加促进微生物生长和繁殖的营养剂。

二:BBR工艺特点
BBR工艺的主要特点如下:
1、 BBR生化工艺采用了生物膜法(BBR生物转盘装置)和活性污泥法(BBR生化池)的组合工艺,以保持Bacillus菌去除各种污染物的高性能。
2、 BBR生化工艺在处理城市污水时,采用污泥回流保持Bacillus菌的数量满足去除有机物的要求;通过内回流保持Bacillus菌的高活性和对各种污染物的高去除率。
3、 为保持Bacillus菌处于优势地位和对氮、磷较高的高去除效率,BBR生化工艺对溶解氧控制到较低的水平(DO不高于1mg/L),与传统生化工艺(一般溶解氧控制在2-4mg/L)相比,BBR生化池所需空气量少很多,这样可以很好地降低能耗;加上BBR装置采用自然通风,这样BBR生化处理工艺相比传统生化处理工艺的能耗约低30-50%(只对生化部分比较)。
4、 BBR生化工艺采用Bacillus菌作为系统的优势菌属,由于其对有机物、氮和磷的独特去除机理和较高的去除率,通过合理的设计,其出水可以满足《城镇污水处理厂污染物排放标准》(GB18918-2002)一级A标准。
5、 由于Bacillus菌本身具有除臭能力,其生化工艺段、污泥处理段可以不需要进行额外的除臭处理,这样可以减少污水处理厂对除臭系统的投资和运行费用。
6、 由于Bacillus菌本身具有自我消毒能力,系统产生的污泥中大肠杆菌属等指标可以比较容易的达到污泥消毒的要求,对污泥后续的最终处置(资源化)创造了较好的条件。
7、 BBR生化系统整体建设用地少于传统工艺。

三:BBR生化工艺核心技术——Bacillus菌的使用
① Bacillus菌介绍
芽孢杆菌(Bacillus),细菌的一科,能形成芽孢(内生孢子)的杆菌或球菌。包括芽孢杆菌属、芽孢乳杆菌属、梭菌属、脱硫肠状菌属和芽孢八叠球菌属等。它们对外界有害因子抵抗力强,分布广,存在于土壤、水、空气以及动物肠道等处。
本工艺中利用的芽孢杆菌,主要包括地衣芽孢杆菌、苛性芽胞杆菌、球形芽孢杆菌、多粘芽孢杆菌、浸麻芽孢杆菌等。
② Bacillus菌去除污染物机理
A. 有机物的去除
Bacillus菌中对蛋白质、淀粉和脂肪有较高的分解能力,去除机理如下:


B. 脱氮机理
同传统的硝化、反硝化脱氮原理不同,Bacillus菌直接吸取胺(有机氮)、氨氮以及铵盐,为微生物所利用,从而进行脱氮,氮元素部分以有机氮的形式进入污泥中,并通过剩余污泥的排放从系统中去除,部分转化成氮气排入空气中。
C. 除磷机理
Bacillus菌属于革兰氏阳性菌。与革兰氏阴性菌相比,革兰氏阳性菌细胞壁比革兰氏阴性菌(在一般活性污泥工艺中使用的菌类)的细胞壁厚而均匀,主要通过肽键来连接肽聚糖构成细胞壁。革兰氏阳性菌的细胞壁包含了大量的磷壁酸。也就是说,在微生物的合成反应中,磷酸盐以磷壁酸的形式进入Bacillus菌的细胞壁中,最后通过剩余污泥的排放从系统中脱磷。
通过Bacillus菌除磷一般去除率在50%以上,为了保证达标,采取辅助化学除磷。
D. 除臭机理
Bacillus菌可将污水中的氨、氨盐、硫化氢等状态的物质吸收,去除了臭气产生成份,大大降低了系统臭气产生量。
E. 消毒机理
Bacillus菌在生长代谢过程中,分泌Bacitracin、Polymyxin、Tyrothicin、Circulin、Gramicidin等抗生素,可以溶解或杀灭处理水中的大肠杆菌及一般细菌等。
由于系统具有自我消毒能力,剩余污泥基本上不需要进行稳定化就可以进入最终的处理和处置过程。
③ Bacillus菌的特点
1、Bacillus菌具有超强的繁殖能力,在低温、高盐度、高压等极具严酷的极限环境中也具有适应能力。
2、可分解蛋白质和将淀粉分解至葡萄糖的能力。
3、可分解脂肪酸。
4、可吸收转化增殖分解后的物质。
5、Bacillus菌属适氮和硫磺素菌种,可将污水中氮素被氧化前的氨、氨盐、硫化氢等状态的物质吸收,去除了臭气产生成份,降低了系统臭气产生量。
6、Bacillus菌具有孢子形成能力,在恶劣环境中能保持活性菌种增殖数量,维持处理能力。
7、可以分泌抗生素,具有杀菌灭菌的功效。
8、可分泌的酵素具有强力的水分解能力,可分解难分解的蛋白质、脂质、核酸等物质,通过对难分解性物质的分解、可大幅提高处理效率。
9、能分泌出一种特殊的粘性物质,具有很强的吸附过滤能力。
10、含有Bacillus菌的活性污泥的脱水性能非常好。

四:BBR生化工艺核心设备——BBR装置
BBR装置中的盘片(生物载体)为Bacillus菌提供了一个生长、繁殖的载体,在BBR装置中保持足够量的Bacillus菌,同时吸附、分解污水中的污染物。其主要特点如下:
1、BBR盘片是采用优质材料聚乙稀基树脂PVDC制造而成的特殊网状结构。
2、该装置空隙率在97%以上,使其具有较大的比表面积,水和空气容易进出,在均一好氧条件下处理效果好而且稳定。
3、BBR盘片质量轻(密度在0.05-0.06g/cm3),不吸水,因此电机功耗较低,后续的保养和操作也较为简便。
4、BBR盘片具有独特的网状结构,使得微生物可以维持较高密度的附着率(约10,000~30,000mg/L),从而可适应流量、有机物负荷变化造成的冲击,对低温也有着极高的适应性。
5、采用优质材料以及强度极高的机械结构,使得本装置可以长期运行。



